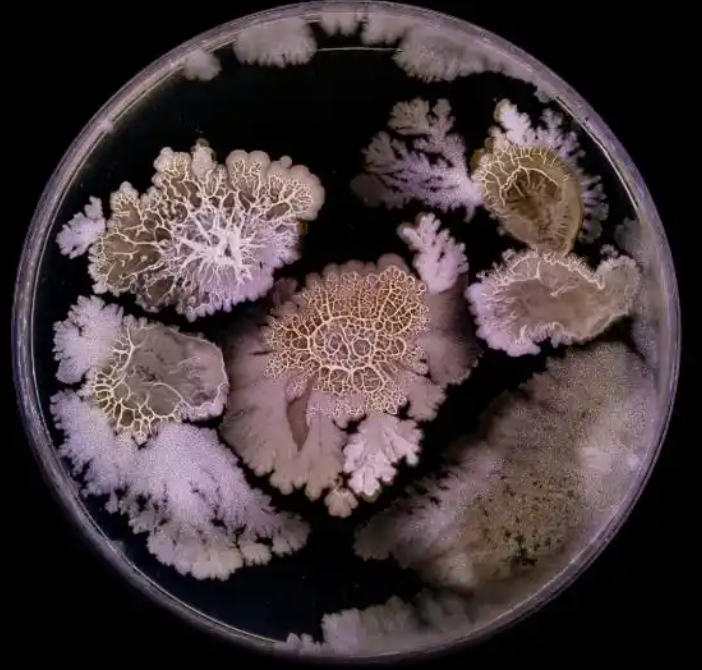
技术资料图片2

6 年
手机商铺
技术资料/正文
155 人阅读发布时间:2025-01-14 09:18
北京日报客户端|记者汪丹
2023年世界微生物数据中心(WDCM)年会日前在深圳举办,会上启动了全球“未培养微生物培养组”计划。在当今世界,微生物被视为一种重要的战略资源,该计划的启动对于微生物资源的可持续利用具有重要意义。
那么,小小微生物与战略资源有何关系?“未培养微生物培养组”计划对微生物资源的可持续利用又有什么重要意义?我们今天请中国科学院微生物研究所工程师王科来聊聊这个话题。
在科学界占据重要一席
我们首先需要深入了解一下地球上的微生物,才能理解它为什么会受到科学家的青睐,又为什么能够在当今科学界占据如此重要的一席。
在地球上,除了大家所熟知的动植物之外,还有另一个重要的生物类群——微生物。顾名思义,微生物的主要特点就是微小,它在科学上的定义是:肉眼难以看清,需要借助光学显微镜或电子显微镜才能观察到的一切微小生物的总称。当然,这个概念也不是绝对的,2022年有科学家在加勒比海地区发现了比果蝇还要大的细菌,还有蘑菇,它们是真菌的子实体,而真菌也属于微生物。
微生物囊括了地球生命之树的多个生物类群。从真核生物中的真菌、原生动物和显微藻类,到原核生物中的细菌、放线菌和原核细胞型微生物支原体、衣原体等,再到没有细胞结构的病毒和亚病毒,它们都属于微生物的范畴。

真菌示意图
微生物虽然个体微小,其作用却很大。38亿年前,微生物作为最早的生命体出现在地球上,并逐步进化成为复杂和多细胞的生命体,最终演化为动植物及人类。人类本身对于微生物而言既是一个寄主也是一个共生体,在人体内的微生物数量多达数百万亿个,总重量可超过1公斤,其中有共生的肠道菌群,也有可能带来疾病的致病寄生菌。有益细菌可以帮助我们消化食物、合成营养素、维护肠道健康、调节免疫系统等,还可以防止有害细菌的侵入和繁殖。
在如今的地球生物圈中,各类生物各司其职,而微生物扮演着“分解者”这一重要角色。它们可以把动植物遗体、粪便等复杂的有机物质逐步分解为简单的无机物,最终以无机物的形式回归到环境中,成为植物等自养生物的营养物质。“分解者”作为生态系统的必要组成成分,维持着生态系统的物质循环,以保证生态系统结构和功能的稳定。如果没有微生物,动植物残骸将淹没地球,各类营养物质不再参与循环,地球生态系统终将ben溃。
微生物对于地球生命起源和生物圈有着不可替代的作用。虽然人类对于微生物的认识和研究仅有300多年,但小小微生物已经为人类的生产生活带来了巨大影响。
在科技前沿展示重要战略潜力
微生物在食品、药物、工业、材料等多个领域也发挥着重要的作用。xi 书记在2022年全国两会期间曾提出:“发展生物科技、生物产业,向植物动物微生物要热量、要蛋白。”微生物中的真菌就是天然的粮仓和优质蛋白质的来源。比如,香菇、木耳、牛肝菌等种类多样的可食用真菌,不仅味道鲜美,还是一类高营养、高蛋白、低脂、低糖、富含维生素和微量元素的健康食品;从真菌和放线菌中提取出的抗生素,在二战期间挽救了数百万人的生命,成为人类对抗细菌性感染病的良药;在工业上,微生物发酵技术为人类带来了面包、酱油、腐乳和酱等食品和调味料,生产出酒精、丁醇等生物燃料,一些微生物制剂和代谢物还可以用作绿色的生物农药。
相对于地球上庞大的微生物家族而言,虽然科学家已培养的微生物种类十分有限,但仍然不妨碍这些微生物资源成为现代生物技术研究以及生物产业发展的重要基石。它们在食品、医药、肥料、饲料、发酵、轻化工、环境保护、纺织、石油、冶金等领域均有广泛应用,所产生的经济和社会价值难以估量,是保障国家粮食安全、生态安全、能源安全等的重要战略资源储备。
培养皿中的真菌和细菌
目前,微生物已经在科技前沿展示了重要的战略潜力。
在微生物生理代谢过程中会产生各种不同的酶,酶可用于催化各类理化反应。比如,检测病毒感染所用到的核酸检测技术,这个实验要在高温下完成,而普通的DNA聚合酶会在高温下失活,科学家从高温热泉中发现的微生物完美解决了这一问题,因为热泉微生物体内的各种生物酶在高温下仍能够保持活性。
利用微生物生产燃料,被看作是解决未来能源危机的一个重要突破口。我们都知道酵母菌可以在无氧条件下,通过体内的酶系统产生乙醇。当前用来生产乙醇的原料主要是甘蔗、马铃薯、高粱等农作物,若大量生产乙醇,会影响到人类的食物来源。而一些木酶、曲霉等微生物体内有纤维素酶,可以把树枝、树叶、稻草、糠壳等分解为葡萄糖,再由酵母菌制造乙醇,由于这一过程的原料都来自绿色植物,所以其生产出来的乙醇也被称作绿色汽油。
作为“分解者”的微生物,除了能降解腐殖质、动植物遗骸和粪便,甚至还可以降解塑料。近年,科学家从垃圾场中发现了一种可以“吃”塑料的细菌,研究发现这种细菌体内可产生一种能分解PET塑料(常用于服装和饮料瓶)的酶,若能提高这些酶的降解效率,白色污染的治理难题将不再困扰人类。
还有真菌,在生长过程中会形成一种叫做菌丝体的营养结构,不仅黏合力超强,还有很高的可塑性和可模压性,使其具有用作新型材料的潜力,现已成功被开发用于包装材料、服装、运动鞋、绝缘材料、房屋建材等多种用途。这种新型材料可用来代替塑料、皮革、聚苯乙烯等难降解、易造成环境污染的传统材料,其天然可降解的特点非常符合当前社会注重环保和可持续发展的要求。
总之,在生物技术高度发展的今天,生物资源已经成为一个国家重要的战略资源,也是衡量国家综合国力的指标之一。因此,制定合理的生物资源保护策略,加强对生物多样性的保护、维持和可持续利用,关系到国民经济发展和社会稳定,关系到国家主权与安全。
为何“99%的微生物物种未被培养”
微生物单个个体十分微小,且在环境中总是多种微生物混杂在一起生存。若想对某一种微生物开展深入的生理、代谢、应用等研究,就得先对它进行单独培养。
作为一类异样生物(又称外养生物,指不能自己合成有机物,须以外源有机物为食物的生物),微生物的生长与繁殖离不开外界的营养,所以,培养微生物首先就是为其准备适宜生长的培养基。由于微生物种类繁多,不同类型的微生物所适宜的培养条件也不一样,比如,以牛肉膏和蛋白胨为主要成分的培养基适合细菌生长,而多数真菌更偏爱以马铃薯和葡萄糖为主要成分的培养基。研究人员将环境样品(如土壤、水、腐殖质等)溶于无菌水后稀释到不同的倍数,均匀涂在培养基表面,密封之后在特定温度、光照、湿度等条件下进行培养。一般几小时到几天之内就能看到微生物菌落,微生物就初步培养成功了。
然而,微生物的培养不是一件容易的事。
目前,地球上已经被描述和认知的原核微生物仅有1.5万种,而科学家对于地球上可能存在的原核微生物物种的数量,尚未达成共识,按照不同的估算方法,估计数量从几万到1万亿不等,数量级差可达亿级。科学家对于真核微生物中的真菌多样性研究相对充分,地球上真菌物种的保守估计数量为220万至380万种,已被认知的真菌有15万种,不及估计数量的6%,其中能够人工培养的真菌远不及十分之一。总体来看,我们对于微生物的认知仅是其冰山一角,“99%的微生物物种未被培养”这一说法毫不夸张。
丰富的物种多样性同样意味着微生物适生环境、生长代谢条件的多样性,也为微生物的针对性培养带来了困难。
首先,人类对微生物多样生长环境的认识无法穷尽,因此在实验室不能完全模拟其生长的原生生态环境,使得某些微生物生长所必需营养元素及生物小分子信号物质在培养基中得不到补充,从而导致目的微生物无法正常生长。还有一些微生物生长于极端环境,如缺氧、高/低温、高/低盐、深海、盐碱地、冰川和洞穴等。当前,科学家还无法完全模拟这些环境条件及物理化学指标,往往只能抓住主要环境因子设计分离培养方法,从中分离出少部分极端环境的微生物物种。
其次,微生物在自然界不是单独存在的,常以群落形式存在,每个微生物群落会包含多个物种甚至多个类型的微生物,各自的生长速率存在较大差异。在分离培养微生物时,同样的培养基及培养条件下,快生长的微生物会迅速富集、大量繁殖,占据较多的生长资源,成为培养基上的优势物种,从而挤占和抑制其他慢生长微生物的生存空间,使其难以大量繁殖形成足够规模的菌落,无法被科学家检测出来。
此外,微生物还普遍存在着休眠策略,在处于不利环境条件时进入可逆的低代谢活动状态。也就是说,若无法模拟出适合其生长的条件,就无法使其从休眠状态中复苏,更别提培养了。
以上多个方面的因素,都是科学家正在面临的微生物培养难题。究其原因,就是无法满足微生物适宜生长的外界条件,从而使其无法正常生长和繁殖。为了突破这一瓶颈,科学家已经做出很多尝试,一是改良传统培养方法,比如在培养基中添加特定的微量元素、群落相互作用的小分子、生物信号等小分子物质以促进微生物的生长,同时尽可能模拟其在自然生长环境中的含氧量、酸碱度、温度等外界条件。二是设计新方法、新技术来培养微生物,比如适用于培养“群居”微生物的共培养方法、保留其自然生态环境的原位培养技术、将样品中不同类型微生物进行筛选分离而后针对性培养的细胞分选技术等。
不过,无论是改良传统方法,还是设计新培养方法,由于操作复杂、实验周期长、设备昂贵等多种因素,是无法针对万级甚至亿级数量的微生物普及使用的。
DNA测序推动微生物科研创新
微生物资源如此重要,人工操作的培养方法又无法在大多数微生物上普及使用,那么有没有其他可以普及的方法呢?科学家认为,信息技术可以为发掘未培养微生物提供新的思路和可能性。
发明于上世纪70年代的DNA测序技术使科学家得以获取生物体的遗传信息、识别功能基因、研究遗传变异等,并迅速在医学、农业、生态学等领域广泛应用。到了本世纪初,传统测序技术经过改良发展成为新一代的高通量测序技术,可以一次并行对大量核酸分子进行平行序列测定,从而快速获取多个生物体的遗传物质。同样的,通过高通量测序技术对环境样品进行测序,可以快速获得其中各种微生物的DNA序列,包括未被培养的微生物物种。
一旦拿到了测序所获得的海量序列和数据,通过海量数据比对和基因组学研究,比如将未培养物种与已培养物种的功能基因相对比,来判断某种未培养微生物可能的适宜生长条件,就可以借助人工智能模型展开分析,对某种微生物的培养条件进行预测和数字模拟。下一步,针对性地配置培养基和设计培养条件,来促进某种特定微生物的生长。
当以上环节顺利完成,就可以快速、大量发现和描述微生物新物种,极大拓展可培养微生物的物种范围,从而获得大量具有重要应用价值的微生物种质资源和数据,为合成生物学研究提供重要功能元件,使微生物更充分地发挥其战略资源价值。
基于上述全新的研究思路和方法,此次举办的世界微生物数据中心年会正式启动了“未培养微生物培养组”计划。这一计划将集合全球微生物学者的力量,开展广泛的宏基因组测序,从中获得海量高质量的微生物基因组及表型数据,不断完善和优化人工智能模型,建立大数据和人工智能指导下的精准培养体系,通过深度融合生物技术/信息技术,实现微生物领域科研模式的创新和突破。
让我们期待微生物世界的神秘面纱逐步被揭开,有害微生物能够得到有效防治,有益微生物也能够更多地被发现从而造福人类。